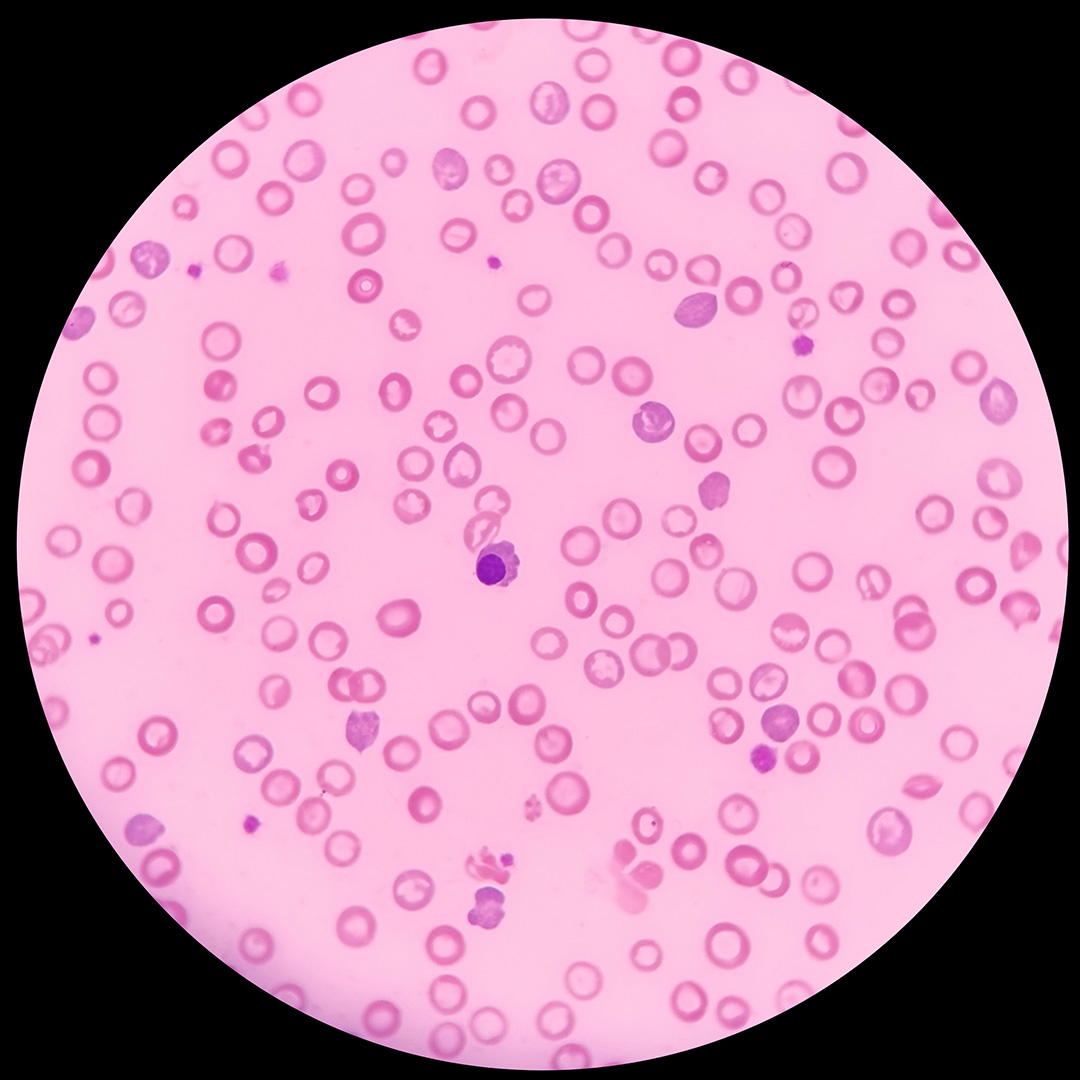
Natural Iron Bild zu Reduction of fatigue*

Natural Iron
- FerroPlant®: purely plant-based curry leaf iron extract
- With iron-saturated Lactoferrin CLN® & vitamin C for improved absorption
- A product of the Cologne List®
- Free from artificial additives, gluten-free, lactose-free1
€35.90
(Delivery time: 1-3 days)
Content:
0.015 kg
(€2,393.33 / kg),
Food-/mandatory information
Collect 35 Health Points (≈ €2.80)
Delivery time: 1-3 days
High-purity plant extracts combined with the immune protein & iron binder lactoferrin.
The unique combination of highly purified lactoferrin CLN®, plant-based curry leaf iron, and vitamin C from rosehip extract in NATURAL IRON can support iron intake, contribute to the reduction of fatigue and tiredness, and support normal immune function.

Natural supplements & superfoods in uncompromising quality
What is Natural Iron?
NATURAL IRON combines iron, lactoferrin, and vitamin C to optimally support the body in daily life. Although iron is a vital, oxygen-binding trace element for humans, it cannot be produced by the body itself. This is where NATURAL IRON comes into play.
The natural vitamin C increases iron absorption and contributes to the reduction of fatigue and tiredness, while iron supports a normal function of the immune system2.
The careful combination of plant-based curry leaf iron, natural vitamin C from rose hips, and the protein lactoferrin is especially appreciated by women (particularly during pregnancy, breastfeeding, or menopause), athletes, and vegetarians. This way, they can continue to achieve great things even in challenging life phases.
Due to the frequent iron deficiency in professional and competitive athletes, our NATURAL IRON is one of the best-selling products in our performance segment to our professional athlete clients.
Why Natural Iron from artgerecht?
- Contributes to the reduction of fatigue and tiredness
- Contributes to supporting the immune system
- Special combination of Lactoferrin, plant-based curry leaf iron, and rose hip extract (Vitamin C)
- With highly purified Lactoferrin CLN® - a bodys own iron-binding immune protein
- Free from artificial additives, gluten-free, lactose-free1
- Laboratory tested; a product from the Cologne List®
Why Natural Iron from artgerecht?
- Contributes to the reduction of fatigue and tiredness
- Contributes to supporting the immune system
- Special combination of Lactoferrin, plant-based curry leaf iron, and rose hip extract (Vitamin C)
- With highly purified Lactoferrin CLN® - a bodys own iron-binding immune protein
- Free from artificial additives, gluten-free, lactose-free1
- Laboratory tested; a product from the Cologne List®
Customer reviews

Ingredients
Curry leaf extract, lactoferrin CLN®, capsule shell hydroxypropylmethylcellulose, rosehip extract
Consumption recommendation: Take 1 capsule once daily with 150 ml of lukewarm water.| Contents | Per Daily Dose (1 Capsule) | % NRV3 |
|---|---|---|
| Lactoferrin CLN® | 100 mg | - |
| Curry Leaf Extract FerroPlant® | 272 mg | - |
| - of which elemental iron | 3 mg | 21 % |
| Rosehip Extract | 489 mg | - |
| - of which Vitamin C | 20 mg | 25 % |
Frequently Asked Questions zu Natural Iron
How does iron deficiency occur?
Iron deficiency is one of the most common micronutrient deficiencies worldwide. It is usually caused by insufficient dietary intake – meaning that not enough of the trace element is absorbed through food. In addition to dietary insufficiency, gastrointestinal disorders or other inflammatory diseases can interfere with the absorption of iron or disturb its distribution in the body. Moreover, during times of increased stress, physical activity, or growth phases (children and adolescents), the bodys demand for iron may increase. Women who lose significant amounts of blood during menstruation may also suffer from iron deficiency. However, the exact cause should be diagnosed by a doctor.
Which foods have a high iron content?
Iron is primarily found in red meat such as beef, veal, and game, as well as in organ meats. Eggs also contain a certain amount of iron (especially in the yolk). Iron is also present in plant-based foods, particularly in (free-range) foods such as green vegetables, various nuts and seeds, as well as herbs and beetroot.
Are there specific physical signs of iron deficiency?
Since iron is closely linked to energy metabolism in the mitochondria and the iron in red blood cells binds oxygen and distributes it throughout the body, iron deficiency has significant effects on performance. The following symptoms may indicate an iron deficiency: pale skin and/or pale mucous membranes, rapid fatigue, difficulty concentrating, increased susceptibility to infections, white ridges on the fingernails or brittle nails, increased hair loss, cracked corners of the mouth, headaches, or dizziness.
Does NATURAL IRON replace the intake of lactoferrin?
The applications for lactoferrin are vast and vary in dosage, method of intake, and combination with other ingredients. In NATURAL IRON, we focus on iron metabolism: The plant-based iron source partially covers the daily requirement, Vitamin C can support the absorption of iron in the gut, and lactoferrin can aid in transporting iron in the body. Therefore, NATURAL IRON does not replace lactoferrin but complements the iron balance.
Why do athletes often have iron deficiency?
Especially in endurance or performance sports, the high physical demands on muscles, the gut, and increased sweating lead to greater consumption and loss of iron. Without proper recovery, the body may absorb even less iron due to chronic stress. If certain dietary habits are added, such as a vegetarian or imbalanced diet, iron deficiency can develop quickly.
Can NATURAL IRON be taken during pregnancy as an iron supplement?
Our combination product NATURAL IRON, made from pure lactoferrin CLN®, plant-based curry leaf iron, and natural vitamin C from rosehip extract, is a useful supplement during pregnancy and breastfeeding, as many women experience increased nutritional needs during this time. However, it is always advisable to consult a healthcare provider.
What is Apo-Lactoferrin or Holo-Lactoferrin?
Lactoferrin, a versatile glycoprotein, primarily exists in two forms: iron-unsaturated (apo-lactoferrin) and iron-saturated (holo-lactoferrin). Apo-Lactoferrin has the ability to effectively bind iron, developing antimicrobial properties by depriving pathogenic organisms of essential iron. Holo-Lactoferrin, on the other hand, already contains bound iron and promotes iron absorption in the body. Both forms are essential for regulating iron metabolism and strengthening the immune system.
Accordingly, for iron deficiency or iron-deficiency anemia, iron-saturated holo-lactoferrin (NATURAL IRON) is recommended, while for supporting the immune system, the immunoregulatory properties of iron-unsaturated apo-lactoferrin (LFERRIN) are emphasized.
What ingredients are in Natural Iron?
| Contents | Per Daily Dose (1 Capsule) | % NRV3 |
|---|---|---|
| Lactoferrin CLN® | 100 mg | - |
| Curry Leaf Extract FerroPlant® | 272 mg | - |
| - of which elemental iron | 3 mg | 21 % |
| Rosehip Extract | 489 mg | - |
| - of which Vitamin C | 20 mg | 25 % |
















